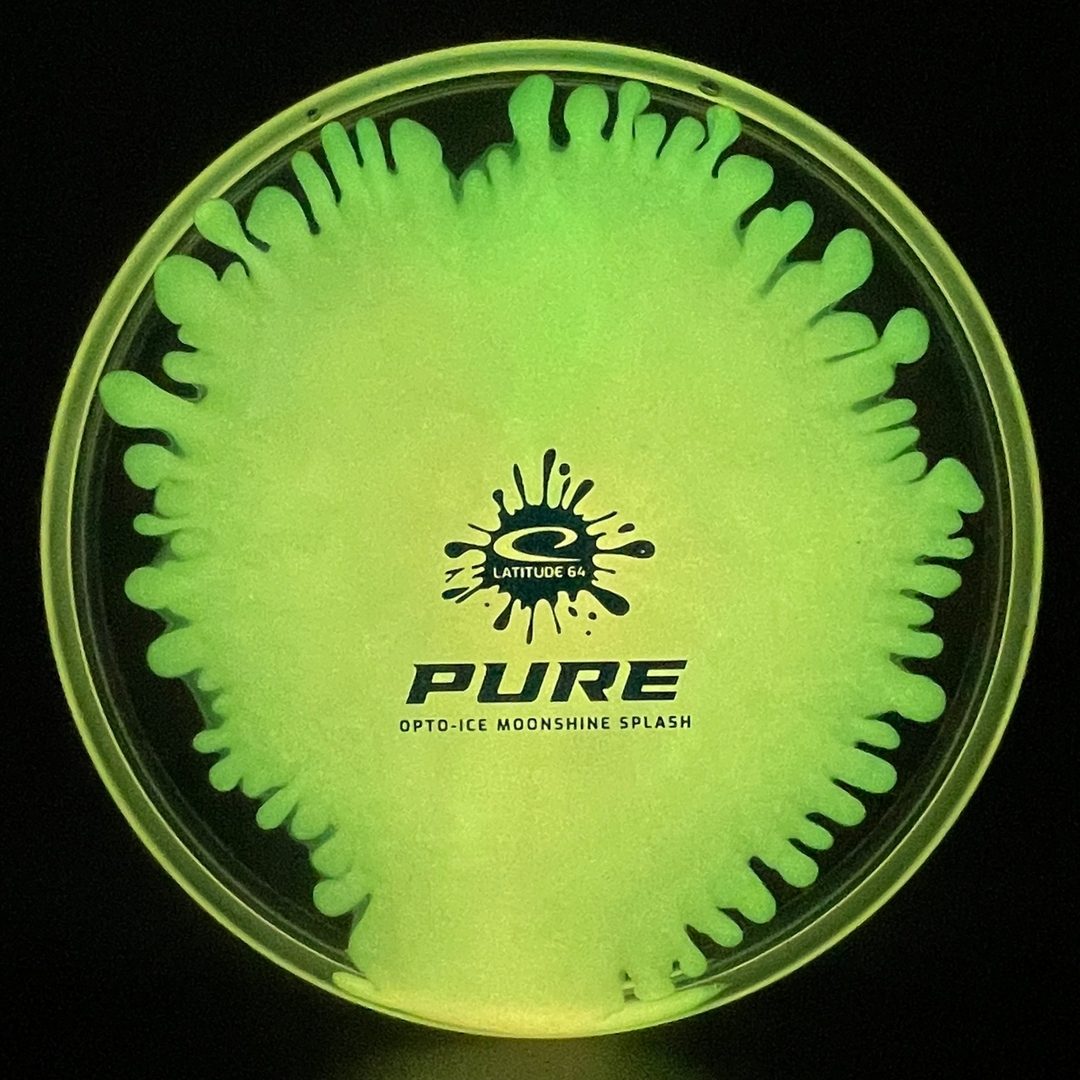
Opto-Ice Moonshine Splash Pure Latitude 64

Latitude 64
Opto-Ice Moonshine Splash Pure
Opto-Ice Moonshine Splash Pure
Couldn't load pickup availability
Product Description
Product Description
3/3/-1/1
The Pure is a straight-flying putter and approach disc with flight numbers 3/3/-1/1. Known for its shallow rim and beadless design, it provides a clean, consistent release for both putting and throwing. The Pure excels at long putts, laser-straight approaches, and gentle turnover lines. Beginners appreciate its easy control, while advanced players rely on its accuracy in wooded fairways. With minimal fade and dependable glide, the Pure is a versatile tool for precision shots.
Opto-Ice Moonshine Splash is a premium Latitude 64 plastic blend that combines durability, grip, and striking aesthetics. The Opto-Ice base provides a clear, stiff feel with excellent durability, while the Moonshine element adds glow-in-the-dark capability for nighttime rounds. The Splash design enhances visual appeal with unique multi-color patterns, making every disc one of a kind. This plastic offers players reliable performance, consistent stability, and a touch of style, ensuring discs look as good as they fly.
Share